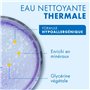
Mixa Lingettes Bébé à l’eau Thermale 4x48

Mixa Lingettes Bébé à l’eau Thermale 4x48
Les Lingettes à l’eau Thermale de Mixa sont spécialement conçues pour nettoyer et protéger la peau des nourrissons. Enrichies en minéraux, elles préviennent le dessèchement cutané.
- Formulé sous contrôle médical : Testé sous contrôle pédiatrique.
- Hypoallergénique : Minimise les risques d’allergie.
- Lingettes d’origine végétale : Respectueuses de la peau et de l’environnement.
Description
Mixa Lingettes Bébé à l’eau Thermale 4x48
Les Lingettes à l’eau Thermale sont spécialement formulées afin de nettoyer et protéger la peau des nourrissons. Enrichie en minéraux, ces lingettes permettent de prévenir le dessèchement cutané. Mixa Bébé, l'expert des peaux sensibles: - Formulé sous contrôle médical. - Testé sous contrôle pédiatrique. - Hypoallergénique pour minimiser les risques d’allergie. Les Lingettes à l’eau Thermale sont spécialement formulées afin de nettoyer et protéger la peau des nourrissons. Enrichie en minéraux, ces lingettes permettent de prévenir le dessèchement cutané. NOUVELLE FORMULE • Hypoallergénique, ces lingettes à l’eau thermale sont conçues avec une formule hautement tolérante pour minimiser les risques de réactions allergiques. • Testée sous contrôle pédiatrique. • Recommandée par les sages femmes. • Lingettes d’origine végétale, offrant une option plus naturelle pour prendre soin de la peau et de l’environnement. INNOVATION PRATIQUE : • Nouveau clapet hygiénique anti-dessèchement qui permet de garder les lingettes à l’abri de l’air et éviter le dessèchement. • Lingettes multi-usages : corps, visage, mains. • Format nomade 48 lingettes : idéal pour vous accompagner dans tous vos déplacements.
Caractéristiques techniques principales

- Formulé sous contrôle médical: Oui
- Testé sous contrôle pédiatrique: Oui
- Hypoallergénique: Oui
Points forts de Mixa Lingettes Bébé à l’eau Thermale 4x48

- Hypoallergénique: Formule hautement tolérante pour minimiser les risques de réactions allergiques.
- Testé sous contrôle pédiatrique: Garantie de sécurité pour les nourrissons.
- Format nomade 48 lingettes: Idéal pour les déplacements et les sorties avec bébé.
Pourquoi choisir Mixa Lingettes Bébé à l’eau Thermale 4x48 ?
Les Lingettes à l’eau Thermale de Mixa sont le choix parfait pour les parents soucieux de la peau délicate de leur bébé. Avec une formule hypoallergénique, testée sous contrôle pédiatrique et recommandée par les professionnels de santé, ces lingettes offrent une solution sûre et efficace pour nettoyer et protéger la peau des nourrissons. Leur format nomade et leur clapet hygiénique les rendent pratiques et hygiéniques, parfaits pour une utilisation quotidienne à la maison ou en déplacement. Offrez à votre bébé le meilleur soin avec les Lingettes à l’eau Thermale de Mixa.
Achetez en ligne sur Isleden pour une livraison rapide et sécurisée. Profitez d’une expérience d’achat en toute confiance avec des garanties et un service de qualité.
Caractéristiques
Livraison Pacifique avec Isleden
🌏 Profitez d’un service de livraison fiable en Nouvelle-Calédonie et en Polynésie Française avec des prix optimisés. Commandez en ligne et recevez vos produits sans mauvaise surprise, avec un suivi et un service client dédié.